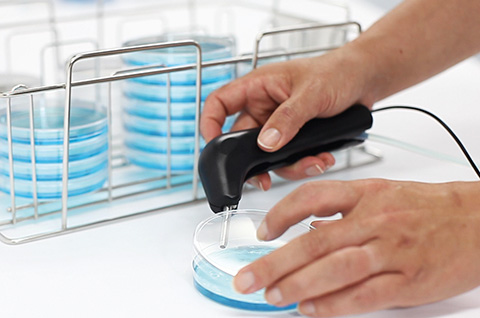

DiluFlow Elite 5 kg
Diluidor gravimétrico 5 kg
Trazabilidad completa
El DiluFlow Elite 5kg diluye automáticamente y en segundos una muestra sólida con la cantidad apropiada de diluyente hasta un peso total de 5 kilos. Su trazabilidad completa permite registrar todas las operaciones realizadas. Es programable y conectable con hasta 6 diluyentes, lo que ofrece la mejor solución para diluciones de cualquier tipo de muestra.
Caracteristicas:
- 225 mL en 8 segundos
- Factor de dilución: de 2 hasta 1000, fracciones personalizables
- Precisión de dilución: > 99 %*
- Peso máximo: 5000 g
- Máximo número de bombas: 2 integradas + 4 externas.
Modo Polvo
DiluFlow Elite, con la opción JumboKit, ofrece un protocolo automatizado para muestras de bajo valor AW (Water Activity – Actividad de Agua) según la norma ISO 6887: leche en polvo, productos deshidratados, cereales…
Conectividad y trazabilidad completa
DiluFlow Elite es programable con 24 programas personalizables.
Su trazabilidad está garantizada por una conexión bidirecional al LIMS.
DiluFlow Elite exporta los datos del análisis a la impresora, USB, ExcelTM, Open OfficeTM, CSV y LIMS.
Aplicaciones
Se usa DiluFlow Elite 5 Kg para análisis microbiológicos en la industria agroalimentaria, control medioambiental e investigación. Es igualmente utilizado en la preparación de muestras al análisis de calidad para el control de materias primas, productos en producción y productos terminados.

Perfil ultra-bajo
¡La apertura de bolsa más amplia y la base de carga más baja del mercado! Gracias a la ergonomía rediseñada, su perfil ultra-bajo permite una mayor comodidad de uso, especialmente dentro de una cabina de flujo laminar.

Bandeja de seguridad extraíble
En caso de salpicaduras, la bandeja es extraíble para una rápida limpieza.
PATENTADO

Sistema de sujeción GeckoGrip
El sistema patentado reemplaza los adhesivos y mantiene la bolsa en su lugar, incluso en superficie húmeda.
PATENTADO
LightCode
Cuenta con un sistema LightCode, un indicador luminoso e intuitivo, que le permite revisar rápidamente el estado del equipo y la precisión de la dilución.
Brazo robótico y protección de boquillas
El brazo robótico permite colocar fácilmente la muestra en la bolsa de análisis sin riesgo de contaminación cruzada. Su fiabilidad está garantizada por pruebas en más de 1.3 millones de ciclos. La placa protectora evita el contacto entre la boquilla y la muestra.
Ventajas

Función tara automática
Modo multi-distribución

Soporte magnético para el BagOpen
